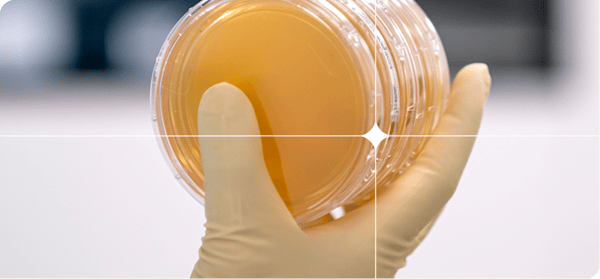
Group 35264
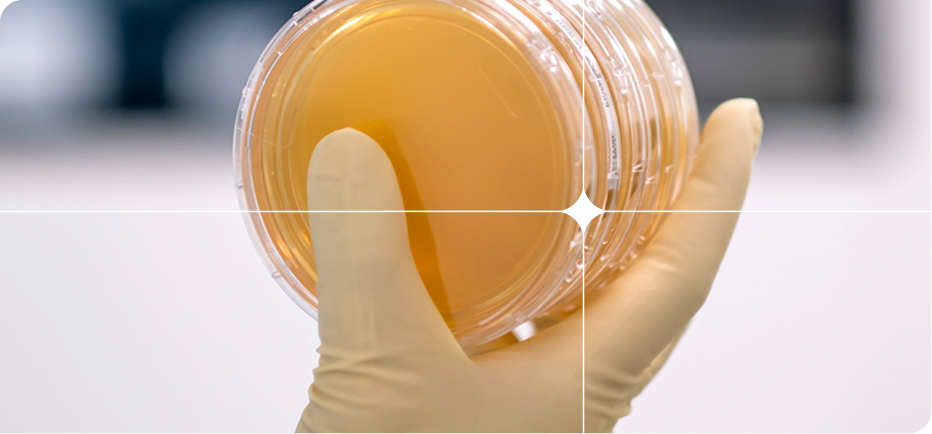
Group 35264

Focus & Expertise
15+ years of exclusive iPSC focus, building deeper expertise for stronger execution
From cell line development to GMP manufacturing, we help bring iPSC-derived cell therapy and regenerative medicine to clinic and scale.

Cellistic supports innovators through flexible entry points across the iPSC-derived therapy journey, combining a full spectrum of CDMO services with pre-established platforms for cell line development and GMP manufacturing — Pulse™ and Echo™ — to help translate advanced programs into scalable production.
Moving beyond autologous or donor-derived approaches? We help establish the iPSC foundation, differentiation process, and platform-enabled workflow needed to advance scalable allogeneic cell therapy.
Already advancing an iPSC-derived program? We help translate promising therapies into GMP-ready, scalable manufacturing processes — from process development through release testing.


See how Cellistic can remove the scientific, operational, and economic barriers to scalable patient delivery.

Cellistic integrates the services, platforms, and expertise required to enable successful iPSC-derived allogeneic cell therapy GMP manufacturing – and we’re continually expanding our capabilities with a single purpose in mind: to help you limit risk, accelerate time to clinic, and reduce costs.
Technology Platforms
CDMO Services
Integrated support from iPSC cell line development through process and analytical development, GMP manufacturing, QC testing, and release.
Cell Therapy Applications
Our iPSC development, differentiation, and manufacturing capabilities support a broad range of immune and regenerative cell therapy programs.
A truly integrated iPSC solution provider from development to GMP
15+ years of exclusive iPSC focus, building deeper expertise for stronger execution
Modular, pre-established platforms that help programs move faster with less risk.
Flexible partnering - from concept to R&D and supply - that adapts to your needs and challenges, while helping reduce tech transfer risk.
Whether you’re pursuing an autologous cell therapy or already have an iPSC-based project underway, Cellistic offers a practical and proven path forward for your cell therapy or regenerative medicine — making it possible to turn a high-potential idea into a viable therapeutic faster and more efficiently.
| iPSC-Derived Allogeneic | Autologous | Donor-Derived Allogeneic | |
|---|---|---|---|
| Your opportunity |
Transfer an existing process to a flexible, full-scale, iPSC-focused CDMO |
Go from one-to-one to one-to-many using our proven platforms |
Overcome limitations to increase scale, consistency, quality, and characterization |
Our headquarters in Mont-Saint-Guibert, Belgium, is home to the first EMA-certified and FDA and PMDA compliant purpose-built iPSC cell therapy GMP manufacturing facility.
With all capabilities in a single location, our clients collaborate closely with our multidisciplinary team, with everyone aligned on the shared goal: developing and manufacturing iPSC-based allogeneic cell therapies as efficiently and cost-effectively as possible.

Let’s start with what’s on your mind – your project plans, your questions about iPSC technology, your most pressing scientific and business drivers. We’re here to listen and, if we’re a good fit, to help you maximize the opportunity and value of your cell therapy.